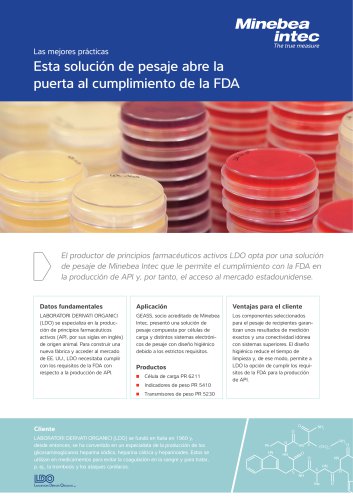

- Catálogos
- Minebea Intec GmbH
- Best Practice Valle Spluga
Extractos del catálogo
El productor de carne de ave Valle Spluga SpA ofrece una gran selección de productos avícolas. Para categorizarla con una precisión y rapidez elevadas, el productor de alimentos solicitó una solución de pesaje de Minebea Intec. Valle Spluga SpA gestiona de forma directa cada fase de su cadena de suministro para garantizar la alta calidad de los productos avícolas. Antes de realizar las entregas a los comercios minoristas y a la gastronomía de alta gama, una fábrica en Gordona elabora el producto deseado a partir de la carne de ave. Surgió la necesidad de una nueva solución de pesaje para aumentar la precisión a la hora de clasificar. Dos pesadoras dinámicas EWK 3010 totalmente integradas pesan y clasifican los productos con gran precisión y a altas velocidades; además, son resistentes a las condiciones medioambientales exigentes. ■ Pesaje de carne de ave con gran precisión (<2 g) ■ Pesaje y clasificación en 6 categorías a una velocidad de 100 piezas por minuto ■ Limpieza sencilla del sistema ■ Conexión a un sistema de supervisión y a SAP para registrar los pesos de cada artículo El cliente Valle Spluga SpA es una empresa alimentaria italiana fundada en Gordona, en la provincia de Sondrio, en 1967, y es reconocida por criar aves de corral y comerciar con su carne. La empresa cuenta con varias ubicaciones por toda Italia especializadas en la producción avícola. La facturación de Valle Spluga SpA ronda los 25 millones de euros con más
Abrir la página 1 del catálogoFinalidad del proyecto e implementación – Galletto Vallespluga en red: con un peso de aprox. 560 graLa empresa alimentaria italiana Valle Spluga SpA produce carmos, destinado principalmente a tiendas gourmet y gastrone de ave de excelente calidad desde hace más de 50 años. nomía de alta gama Los pollos tienen la libertad de vagar por los amplios recintos cerca de los Alpes, donde disfrutan de agua fresca Valle Spluga SpA impuso como requisito general que el proy aire de la montaña con una dieta a base de plantas como ceso fuera rápido. Al mismo tiempo, todo el sistema debía maíz, soja y trigo....
Abrir la página 2 del catálogoTodos los catálogos y folletos técnicos Minebea Intec GmbH
- Indicador de peso MiNexx® C
8 Páginas
- Best Practice Avio
2 Páginas
- Best Practice LDO
2 Páginas
- PR 5220 Brochure es
4 Páginas
- Best Practice HPC
2 Páginas
- Best Practice Anona
2 Páginas
- Best Practice CanSino
2 Páginas
- Best Practice MIXACO
2 Páginas
- Best Practice Pharmatec
2 Páginas
- Best Practice Boehringer Ingelheim
2 Páginas
- Best Practice Ramsauer
2 Páginas
- Best Practice Braskem
2 Páginas
- Best Practice ADLER
2 Páginas
- Best Practice SABIC
2 Páginas
- Best Practice Bhilai Steel Plant
2 Páginas
- Best Practice Confectionery Company
2 Páginas
- Best Practice Sinovac
2 Páginas
- Hoja de Datos LC Tigo
5 Páginas
- Hoja de datos LC Aluminium
4 Páginas
- Best Practice Pacific Nut
2 Páginas
- Best Practice Weinrich
2 Páginas
- hoja de datos BCL-A
1 Página
- Hoja de datos U2D1
2 Páginas
- hoja de datos CB17
1 Página
- Datasheet Dypipe ES
6 Páginas
- Datasheet X2 (ES)
4 Páginas
- Sistemas de inspección por rayos X
16 Páginas
- Pesaje en tanque de proceso y en silo
28 Páginas
- Minebea Intec GmbH Brochure es
16 Páginas
- Básculas industriales de mesa y de suelo
24 Páginas
- Mejores prácticas: CanSino
2 Páginas
- Mejores prácticas: Pacific Nut
2 Páginas
- Mejores prácticas: Ramsauer
2 Páginas
- Mejores prácticas Adler Lacke
2 Páginas
- Mejores prácticas Stevin Rock
2 Páginas
- Hoja de datos PR 5211
4 Páginas
- Datasheet PR 6246
4 Páginas
- Datasheet Dylight S
4 Páginas
- Brochure Bench and Floor Scales
24 Páginas
- Datasheet Weight Transmitter Link E
3 Páginas
- Célula de carga Minebea Intec
- Software resolutivo de gestión
- Software de automatización
- Célula de carga de tracción compresión Minebea Intec
- Software de proceso
- Célula de carga de acero Minebea Intec
- Software Windows
- Célula de carga de galga extensométrica
- Balanza digital Minebea Intec
- Célula de carga de acero inoxidable Minebea Intec
- Célula de carga de pesaje Minebea Intec
- Software de vigilancia
- Software resolutivo industrial
- Software de interfaz
- Balanza de plataforma Minebea Intec
- Balanza de acero inoxidable Minebea Intec
- Célula de carga tipo viga
- Indicador de pesaje Minebea Intec
- Sistema de inspección
- Balanza kilogramo